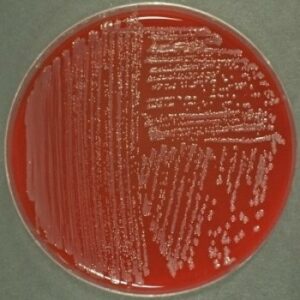
تست ویدال در لوله

Widal در آزمایش خون چیست
تست ویدال یکی از روش هایی است که ممکن است برای کمک به تشخیص احتمالی تب روده، که به عنوان تب حصبه نیز شناخته می شود، استفاده شود. اگرچه این آزمایش دیگر معمولاً در ایالات متحده یا سایر کشورهای توسعه یافته انجام نمی شود، اما هنوز در بسیاری از کشورهای در حال ظهور که تب روده بومی است و منابع محدودی نیاز به استفاده از جایگزین های آزمایشی سریع و مقرون به صرفه دارند، استفاده می شود.
در حالی که انجام این روش آسان است، نگرانی ها در مورد قابلیت اطمینان تست Widal باقی می ماند. برای تب تیفوئید اختصاصی نیست و زمانی که فرد عفونت نداشته باشد می تواند مثبت باشد.
تب روده ای
تب روده ای یک بیماری تهدید کننده زندگی است که در اثر عفونت با باکتری سالمونلا انتریکا سروتیپ تیفی (S. typhi) ایجاد می شود که معمولاً از طریق غذا و نوشیدنی های آلوده به مواد مدفوع منتقل می شود. این بیماری با علائمی مانند تب بالا، خستگی، سردرد، درد شکم، اسهال یا یبوست، کاهش وزن و بثورات موسوم به “rose spots” همراه است. تشخیص و درمان به موقع مهم است زیرا عوارض جدی، از جمله خونریزی شدید روده یا سوراخ شدن روده، می تواند در عرض چند هفته ایجاد شود.این عفونت در ایالات متحده و سایر کشورهای صنعتی نادر است، اما در کشورهای در حال توسعه، از جمله هند، بخشهایی از جنوب، شرق و جنوب شرق آسیا، و کشورهای آفریقا، دریای کارائیب، آمریکای مرکزی و جنوبی و اروپای شرقی شایعتر است. موارد تب روده ای در ایالات متحده معمولاً به مسافران این مناطق بومی نسبت داده می شود.
تشخیص
در ایالات متحده و سایر کشورهای توسعه یافته، آزمایش تب روده معمولاً شامل کشت خون برای شناسایی باکتری در هفته اول تب است. کشت مدفوع، ادرار یا مغز استخوان نیز ممکن است انجام شود. با این حال، کشت خون در مناطقی از جهان که منابع لازم برای تجهیزات خودکار را ندارند، میتواند زمان بر باشد. در کشورهای در حال توسعه، مانند کشورهای آفریقایی، آزمون Widal همچنان به جای کشت مورد استفاده قرار می گیرد زیرا اجرای آن سریع تر، ساده تر و کم هزینه تر است.سازمان بهداشت جهانی (WHO) اعلام کرده است که با توجه به عوامل مختلفی که می تواند بر نتایج آزمایش ویدال تأثیر بگذارد، بهتر است زیاد به این آزمایش اعتماد نکنید. در عوض WHO استفاده از کشت ها را در صورت امکان توصیه میکند. با این حال، تا زمانی که گزینه ساده، ارزان و قابل اعتماد دیگری در دسترس قرار گیرد، استفاده از آزمون Widal احتمالاً در کشورهایی با منابع محدود ادامه خواهد داشت.
تستهای آنتیبادی سریعتر جدیدتری برای تب حصبه به صورت تجاری در دسترس هستند، که چندین مورد از آنها در مطالعات مقایسهای قابلیت اطمینان آنها گنجانده شدهاند، برای مثال در هند و آفریقا. به نظر می رسد یافته ها در مورد اینکه آیا هر کدام به اندازه کشت خون برای تشخیص این عفونت قابل اعتماد هستند، متفاوت است.
روش انجام تست ویدال
تست ویدال ممکن است به روش لوله یا اسلایدی انجام شود.
روش انجام تست ویدال در لوله
Widal (روش لوله)
- یک نمونه خون از بیمار جمع آوری کنید و بگذارید لخته شود.
- پس از تشکیل لخته، نمونه را سانتریفیوژ کنید تا سرم از سلول ها جدا شود.
- چند لوله آزمایش را با نام بیمار و تاریخ برچسب بزنید.
- رقت متفاوتی از محلول آنتی ژن را به هر یک از لوله های آزمایش اضافه کنید.
- مقدار ثابتی از سرم بیمار را به هر لوله آزمایش اضافه کنید.
- محتویات هر لوله آزمایش را کاملاً با هم ترکیب کنید.
- لوله های آزمایش را به مدت ۲۴ ساعت در دمای ۳۷ درجه سانتیگراد انکوبه کنید.
- لوله های آزمایش را از نظر آگلوتیناسیون بررسی کنید. تجمع باکتری ها نشان دهنده یک نتیجه مثبت است.
روش انجام تست ویدال اسلایدی
یک نمونه خون از بیمار جمع آوری کنید و بگذارید لخته شود.
- پس از تشکیل لخته، نمونه را سانتریفیوژ کنید تا سرم از سلول ها جدا شود.
- یک قطره از سرم را روی یک لام شیشه ای تمیز بریزید و نام بیمار و تاریخ را روی آن برچسب بزنید.
- یک قطره محلول آنتی ژن (حاوی سالمونلا تیفی کشته شده و سالمونلا پاراتیفی) به قطره سرم اضافه کنید.
- دو قطره را با استفاده از یک خلال دندان تمیز یا میله شیشه ای مخلوط کنید و مطمئن شوید که کاملاً با هم ترکیب شده اند.
- لام را به مدت ۴ دقیقه به آرامی بچرخانید تا آگلوتیناسیون رخ دهد. آگلوتیناسیون به تجمع باکتری ها گفته می شود که در اثر تعامل بین آنتی بادی های سرم و آنتی ژن های موجود در محلول ایجاد می شود.لام را زیر میکروسکوپ با بزرگنمایی ۴۰ برابر بررسی کنید تا به دنبال آگلوتیناسیون باشید. تجمع باکتری ها نشان دهنده یک نتیجه مثبت است.
نتایج مثبت کاذب در تست ویدال
در هر دو روش، افزایش تیتر آنتی بادی در طول زمان نشان دهنده تشخیص مثبت تب روده است. با این حال، یک نتیجه مثبت منفرد برای تشخیص کافی نیست، زیرا نتایج مثبت کاذب می تواند به دلیل عفونت های دیگر یا قرار گرفتن قبلی در معرض باکتری رخ دهد. بنابراین، تست Widal اغلب همراه با سایر تست های تشخیصی و علائم بالینی برای تایید وجود تب روده استفاده می شود.
نتیجه آزمایش ویدال
اگر سرم بیمار دارای آنتی بادی علیه سالمونلا تیفی باشد، با آنتی ژن موجود در معرف واکنش داده و باعث آگلوتیناسیون قابل مشاهده در آزمایش اسلاید می شود. این تیتر آنتی بادی حداکثر رقت نمونه سرم بیمار است که منجر به آگلوتیناسیون بصری واضح با سوسپانسیون های آنتی ژن تست Widal می شود.هیچ استانداردی برای محدوده طبیعی آزمایش خون گسترده وجود ندارد. نتیجه آزمایش مثبت نشان می دهد که سیستم ایمنی بدن در پاسخ به عفونت، آنتی بادی هایی را علیه میکروب های سالمونلا تیفی و سالمونلا پاراتیفی ایجاد کرده است.. با این حال، نتایج آزمایش باید در ارتباط با علائم بالینی و سابقه بیمار تفسیر شود. لازم به ذکر است که پزشک باید تفسیر یافته های آزمایش را انجام دهد.




بدون دیدگاه